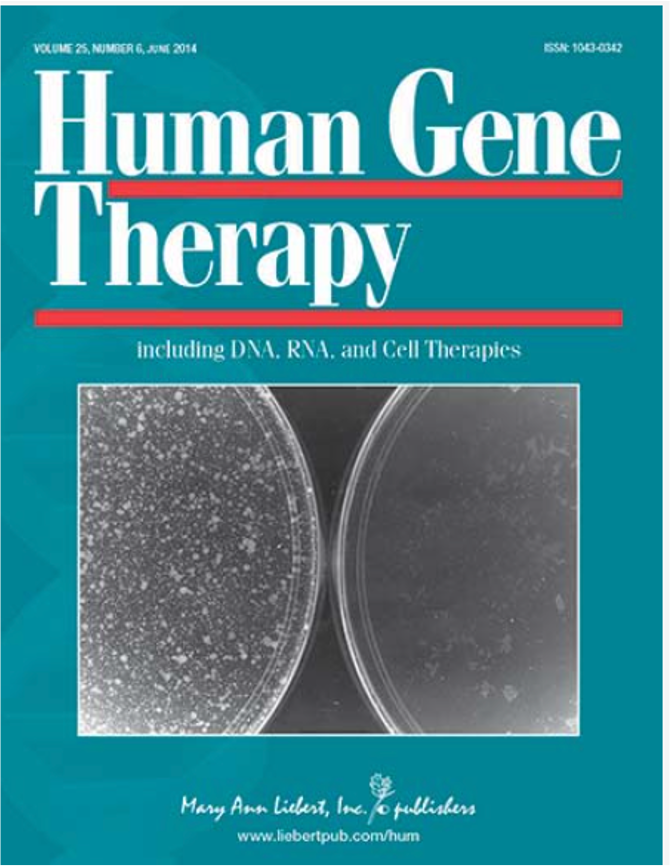

Gene journal
Какие цвета подходят под фиолетовый цвет
Справочная кончаловского
Нко отделения
Камины в интерьерах квартир фото
Формирование кредитной политики организации
Мунтун мобайл
Чем отличается hb3 от hb4
Форточка листа
Вязание крючком английская резинка схема вязания
Ссылка на канал в дзен
Коллекция марелла
Пюре манго агробар
Свая винтовая 6000
Gene journal 81 фото